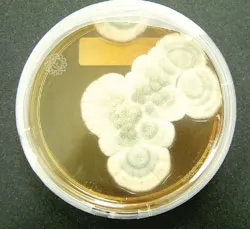
Thành công  nhờ... sự tình cờ

Trong lịch sử giải Nobel Y học, nhiều bước tiến mang tính đột phá ở lĩnh vực chẩn đoán, điều trị đã đạt được thành công nhờ những sự tình cờ đầy may mắn.
- Ngọn gió vô tình mang lại thuốc kháng sinh và giải Nobel 1945
Nấm Penicillin notatum
Năm 1929, nhà sinh vật học Alexander Fleming nuôi cấy vi khuẩn Staphylococus trong môi trường thạch để chúng phát triển.
Mùa hè Luân Đôn năm ấy oi bức khiến các cửa sổ phòng thí nghiệm được mở rộng, những ngọn gió vô tình mang theo những hạt bụi rơi vào môi trường cấy.
Sau đó, quan sát trên kính hiển vi, nhà bác học Fleming đã ngạc nhiên thấy có những nấm mốc mọc trên thạch và điều ngạc nhiên hơn nữa là chung quanh nơi nấm mọc, vi khuẩn đã bị tiêu diệt, một vòng trắng trong hiện ra chung quanh nấm mốc.
Sau nhiều lần thử nghiệm, ông đã nuôi cấy được nấm Penicillin notatum có khả năng tiêu diệt được nhiều loại vi trùng gây bệnh. Và tên kháng sinh (antibiotic phát xuất từ tiếng La tinh: anti - chống lại, bios - sự sống) ra đời.
Năm 1941, cùng với Chain và Florey, liệu pháp kháng sinh chống các bệnh nhiễm trùng trên người chính thức ra đời và mang lại giải Nobel Y học cho cả ba nhà bác học trên vào năm 1945. Công nghiệp điều chế thuốc kháng sinh bắt đầu phát triển.
- Quý ông hưởng lợi từ sự tình cờ dẫn đến giải Nobel y học 1998
Giải Nobel Y học 1998 được trao cho ba nhà bác học thuộc các trường đại học Hoa Kỳ, đó là các GS Robert F. Furchgott (82 tuổi), Louis J. Ignarro (57 tuổi), Ferid Murad (62 tuổi) với các công trình nghiên cứu về Oxid nitric, một cái tên hoàn toàn xa lạ với nhiều người.
Trên con đường tìm kiếm những hoạt chất mới trị cơn đau thắt ngực, người ta phát hiện ra phân tử Sildenafil citrat. Trong khi đó, ở một thí nghiệm khác, người ta phát hiện hoạt chất Sildenafil có tác dụng phụ kỳ diệu khiến bộ phận sinh dục của chuột thí nghiệm cương cứng.
Thế là công cuộc nghiên cứu được chuyển hướng qua điều trị bệnh rối loạn cương dương (ED: Erectile Dysfunction) từ năm 1994 tại Mỹ rồi sau đó Anh, Tây Ban Nha, Ý, Pháp.
Với 5.000 bệnh nhân thử nghiệm, 85% đạt được cương cứng và 70% đạt được yêu cầu trong sinh hoạt chăn gối. Hoạt tính của chất này có liên quan đến vai trò của Oxid nitric (NO). NO tăng hay giảm sẽ ảnh hưởng đến sự cương cứng nhiều hay ít và Sildenafil giúp cho Oxid nitric tăng tác dụng để trị bất lực hay rối loạn cương dương.
Tên khoa học Sildenafil nghe xa lạ nhưng ngày nay, hầu như toàn thế giới đều biết đến tên loại thuốc chứa thành phần này: Viagra.
- Nobel y học 2006 từ sự tình cờ đổi màu hoa

Hoa péturinas
Giải Nobel Y học 2006 được trao cho hai nhà bác học trẻ của Hoa Kỳ trên lĩnh vực sinh học phân tử về gen di truyền từ cơ chế tác động của một phân tử ARN mới gọi là ARN interférence (ARNi).
Ít ai biết được rằng sự quan tâm nghiên cứu về gen di truyền lại đến từ sự tình cờ biến đổi màu sắc của một loài hoa.
Đó là vào năm 1990, một nhà sinh vật học Mỹ muốn tăng thêm sắc tím cho hoa péturinas nên tìm cách ghép gen tăng cường màu tím vào hệ di truyền của cây.
Kết quả thật ngạc nhiên: hoa không những không tím thêm mà lại có màu trắng. Sự tình cờ ngoài ý muốn này đã khiến các nhà khoa học quan tâm nghiên cứu và đến năm 1998, hai nhà sinh vật học trẻ Andrew Z. Fire (46 tuổi) và Craig C. Mello (47 tuổi) đã công bố trên tạp chí khoa học Nature (ngày 19-2-1998) báo cáo nghiên cứu khoa học chứng minh kết quả thực nghiệm trên loại giun tròn Caenorhabditis elegans và ruồi giấm phương pháp có thể bất hoạt gen bằng cách can thiệp lên ARN messager (ARNm), một cấu trúc thiết yếu truyền thông tin từ phân tử ADN đến các protein.
Hiện tượng tình cờ quan sát thấy từ 10 năm trước nay mới được hiểu rõ. Từ đó, chứng minh được cơ chế phát sinh ARN giao thoa, mở ra con đường mới để nghiên cứu gen liệu pháp, chế tạo ra các liệu pháp hữu hiệu chống lại bệnh ung thư và các bệnh nhiễm vi khuẩn, virus... từ gen di truyền.
DS. Trương Tất Thọ

























